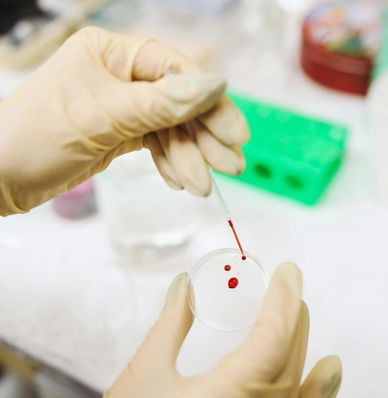

We are proud to share that Megan’s Rose of Hope has made a donation to the Newcastle Cancer Centre Pharmacology Group (NCCPG) — a dedicated team of highly experienced researchers working at the forefront of cancer treatment.
The NCCPG specialises in clinical pharmacology within oncology and has a proven track record of running vital studies across many phases of clinical trials. They work in close collaboration with a wide range of organisations, including Cancer Research UK’s Centre for Drug Development, academic institutions, and pharmaceutical and biotech companies.
Their research focuses on developing innovative pharmacokinetic and pharmacodynamic biomarker assays, allowing detailed analysis of clinical samples. This work has directly contributed to:
• The development of new anti-cancer drugs
• The introduction of new treatment guidelines
• The development of an infant chemotherapy dosing guidance website
• The creation of novel drug formulations for both adult and paediatric cancer patients
One of the group’s most impactful achievements is the establishment of a national therapeutic drug monitoring (TDM) service, now considered gold standard in dosing chemotherapy drugs for some of the most complex childhood cancer cases.
Therapeutic drug monitoring involves measuring drug levels — often from very small blood samples — to tailor treatment to the individual patient. This allows doctors to adjust doses to improve treatment effectiveness while reducing side effects, making chemotherapy kinder and safer for children.

Too often, teenagers and young adults with cancer fall into a gap between “childhood” and “adult” care. This can mean fewer clinical trials, fewer tailored treatments, and less of the support they need at such a crucial stage of life.
That’s why this research matters so much. By recognising teenagers and young adults as their own group, The Institute of Cancer Research is working to give them equal access to the right treatments, trials, and support networks.
Thanks to the generosity of our amazing supporters, donations we’ve raised are helping to fund this vital work. Together, we are giving young people and their families hope for kinder, more effective treatments and a brighter future💛
A huge thank you to @icr_london for letting us be a part of this important work, and for their dedication to ensuring no young person is overlooked.
We are honoured that Megan’s Rose of Hope has been part of such an important research project led by our friends at @childrenscancerresearchfund , alongside The Bradley Lowery Foundation.In 2024, Friends of Rosie completed a £145,000 research project into a revolutionary new blood test (liquid biopsy) to help diagnose and monitor Ewing Sarcoma, a rare childhood bone cancer.
This pioneering study has shown promising results, with researchers working to identify:
🔬 Which blood tests are most effective
🔬 The best ways to detect Ewing Sarcoma early
🔬 How to monitor whether treatment is working or if the cancer returns
Following this success, the research team are now looking to move forward into a wider European study, offering even greater hope for earlier diagnosis and better outcomes for children facing this devastating disease.
We are so grateful to Friends of Rosie for leading this vital research, and proud that Megan’s Rose of Hope could contribute. Together, we will continue to bring hope and make a difference for children with cancer🎗️